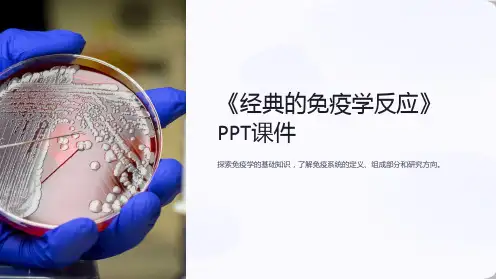

经典免疫学技术
- 格式:ppt
- 大小:1.54 MB
- 文档页数:35

免疫学实验方法免疫学实验方法是免疫学研究的重要部分,它通过一系列的技术手段来识别、分析免疫系统中的各种生物分子、细胞和组织,以及它们之间的相互作用。
这些方法在免疫学领域广泛应用于疾病诊断、药物研发、疫苗研究等方面,对促进免疫学的发展和应用发挥了重要作用。
下面将介绍一些常用的免疫学实验方法。
一、ELISA法ELISA(酶联免疫吸附试验)是一种用于检测抗体或抗原的免疫学实验方法。
该方法通过将待测抗体或抗原与固相物质结合,再加入酶标记的二抗来进行标记,最后通过酶底物的底物变色反应或荧光底物的发光反应来检测待测抗体或抗原的存在量。
二、流式细胞仪流式细胞仪是一种用于分析和计数悬浮细胞的仪器,它利用激光照射细胞,通过细胞膜上的特异性抗体标记来检测细胞的表面标记物和内部细胞器的性质和分布,对免疫细胞的表型和功能进行高效的分析。
三、免疫印迹法免疫印迹法是一种用于检测蛋白质的免疫学实验方法,通过电泳将待测蛋白分离,再将其转移到膜上,最后使用特异性抗体和标记的二抗来检测待测蛋白的存在量和大小。
四、免疫组化法免疫组化法是一种用于检测组织中特定蛋白的免疫学实验方法,通过将组织切片后进行脱水、脱脂和脱水处理,再使用特异性的抗体来标记待测蛋白,并观察标记物的颜色变化或发光情况来确定蛋白的位置和表达量。
五、免疫沉淀法免疫沉淀法是一种用于检测蛋白相互作用的免疫学实验方法,通过将待测抗体与蛋白结合,再使用蛋白A/G琼脂糖或磁珠等材料将蛋白抗原免疫沉淀下来,最后使用核酸酶或质谱技术来分析蛋白的互作关系。
以上介绍的是一些常用的免疫学实验方法,它们在免疫学研究中起着举足轻重的作用,不仅在科研领域有重要应用,同时在临床诊断和治疗中也有着广泛的运用。
希望以上内容能够对您有所帮助。


免疫学的发展史
1、免疫学科的开创时期
18世纪,英国医生Jenner观察到挤奶女工在患牛痘
后不易得天花的事实后,发明了用牛痘苗预防天花的方法,开创了人工免疫,这可视为免疫学科的建立
2、经典免疫学时期【19~2o世纪初)
①法国免疫学家P~teur和德国细菌学家Koch,在方法学上创造性地解决了细菌的分离培养
②发明了酿毒疫苗,创建了人工主动免疫方法。
1881年P'dstet
③发现了抗毒索,创立了人工被动免疫方。
Behfing于1891年
④人体免疫系统的解剖结构和生理功能的研究。
如比利时Border发
⑤形成了抗原抗体概念,建立起血清学检测方法
⑥抗原抗体理化性质的研究以及抗原抗体反应特异性的化学基础研究
⑦体液免疫与细胞免疫学说的提出
⑧对免疫效应双重性的认识
3、近代免疫学时期(20世纪初~20世纪50年代)
1942年,Chase等人深人研究Koch现象.证明了结核菌素反应不是由抗体引起,而是由致敬细狍引起,证明了机体免疫是包括体液免疫和细胞免疫两种形式的
1945年,Owe.发现天然耐受
澳大利亚免疫学家Burl~ 提出了自身耐受形成的假说
1953年,Bellhggham,Medav,-ar在小鼠俸内成功地进行了人工诱导耐受实验,给予Butt~ 学说以有力支持。
同年,Grubar等人建立的免疫电泳技术促进了对蛋白质抗原性的免疫化学分斩,从而发现了抗体分子的不均一性,但抗体的纯化遇到了困难。
1958年,Burbe【提出关于抗体生成的克隆选择学说
4、现代免疫学时期c20世纪60年代~2l世纪初)。

免疫学十大经典实验免疫学是研究机体免疫系统的科学,它关注的是人体如何识别、应对和清除外来病原体以及自身异常细胞的过程。
在免疫学的发展历程中,通过一系列经典实验的探索,我们逐渐了解了免疫系统的工作原理和机制。
下面列举了十个免疫学的经典实验。
1. 阿尔密特实验(Almroth Wright's Experiment)阿尔密特实验是免疫学的开创性实验之一,他通过注射不同剂量的破伤风毒素来研究机体对破伤风的免疫反应。
实验结果表明,注射较小剂量的破伤风毒素可以引起机体免疫反应,产生保护性抗体,从而提高机体对破伤风的抵抗能力。
2. 杰奇-梅特克夫实验(Jules Bordet and Octave Gengou's Experiment)杰奇-梅特克夫实验是用来检测补体的经典实验,补体是一组血浆中的蛋白质,可以识别和破坏病原体。
实验中,研究者将红细胞与抗原结合,然后加入血清,通过观察红细胞的溶解来判断补体的活性。
3. 布瓦尔-杜塞特实验(Paul Ehrlich and Emil von Behring's Experiment)布瓦尔-杜塞特实验是研究抗体的经典实验,抗体是免疫系统产生的一种特殊蛋白质,可以识别和结合病原体,从而协助机体清除病原体。
实验中,研究者注射不同剂量的破伤风毒素到动物体内,观察抗体产生的情况。
4. 阿夫拉螺旋体实验(Alexander Fleming's Experiment)阿夫拉螺旋体实验是研究抗生素的经典实验之一,通过观察抗生素对细菌生长的影响来评估抗生素的效果。
实验中,研究者将阿夫拉螺旋体接种在培养皿中,然后在不同区域施加抗生素,观察细菌的生长情况。
5. 麻风病菌实验(Albert Calmette's Experiment)麻风病菌实验是研究麻风病菌的经典实验之一,通过接种麻风病菌到动物体内,观察动物的症状和病理变化,以及麻风病菌的传播途径和致病机制。

免疫学经典书籍
1.《免疫生物学》(Immunobiology):本书由美国哈佛大学免疫学专家CharlesJaneway等人所著,是免疫学领域最重要的经典教材之一。
2.《免疫学原理》(Principles of Immunology):本书由美国免疫学界泰斗Abul K. Abbas等人所著,是一本系统、全面的免疫学教材。
3.《免疫学基础》(Basic Immunology):本书由美国免疫学专家William E. Paul等人所著,是一本深入浅出、生动易懂的免疫学教材。
4.《免疫学简史》(A Short History of Immunology):本书由英国免疫学家Arthur M. Silverstein所著,介绍了免疫学的发展历程和重要人物,是一本充满趣味性的免疫学读物。
5.《免疫学实验技术手册》(Manual of Immunological Methods):本书由美国免疫学专家Nima Rezaei等人所著,详细介绍了常用的免疫学实验技术,是免疫学实验室必备的参考书。
以上书籍均为免疫学领域的经典之作,对于免疫学爱好者和从事免疫学研究的人员来说,都是必读的好书。
- 1 -。

医学免疫学沉淀反应在医学免疫学的领域中,沉淀反应是一项十分重要的实验技术。
它不仅有助于我们对疾病的诊断和监测,还在科研领域发挥着关键作用。
沉淀反应的原理其实并不复杂。
简单来说,就是当可溶性抗原与相应抗体在特定条件下结合时,会形成肉眼可见的沉淀物。
这一过程基于抗原与抗体的特异性结合,只有当两者的结构和电荷相互匹配时,才能发生有效的反应。
沉淀反应的类型多种多样。
其中,环状沉淀反应是比较经典的一种。
在这种反应中,将抗原溶液小心地叠加在抗体溶液之上,在两者的界面处,如果存在对应的抗原抗体,就会形成白色的沉淀环。
这种方法虽然简单直观,但灵敏度相对较低,如今在实际应用中已经不那么常见。
另一种常见的沉淀反应是絮状沉淀反应。
在这个实验中,抗原和抗体溶液混合后,会出现肉眼可见的絮状沉淀物。
然而,这种反应的结果判断往往比较主观,容易受到多种因素的影响,比如溶液的浓度、温度以及混合的方式等。
相较于上述两种方法,免疫比浊法在现代医学中的应用更为广泛。
它通过测量溶液中抗原抗体复合物形成后导致的浊度变化,来定量分析抗原或抗体的含量。
这种方法具有快速、准确、自动化程度高等优点,尤其适用于临床实验室对大量样本的检测。
在实际应用中,沉淀反应有着广泛的用途。
比如在疾病诊断方面,当我们怀疑一个人感染了某种病原体时,可以通过检测患者血清中针对该病原体的特异性抗体来辅助诊断。
如果检测结果显示存在相应的沉淀反应,就提示患者可能已经感染了该病原体。
再比如,在血液制品的质量检测中,沉淀反应可以帮助检测其中是否存在杂质或异常蛋白。
这对于保障血液制品的安全性和有效性至关重要。
不仅如此,沉淀反应在自身免疫性疾病的诊断中也发挥着重要作用。
自身免疫性疾病患者体内常常会产生针对自身组织或细胞的抗体,通过沉淀反应检测这些抗体的存在,可以为疾病的诊断提供有力的依据。
然而,沉淀反应也并非完美无缺。
它可能会受到一些因素的干扰。
比如,标本的采集和处理不当可能会影响抗原或抗体的活性,从而导致假阴性或假阳性结果。


医学免疫学(Medical immunology)【名词解释】1、免疫(immunity)免疫是指机体对对“自己”或“非己”的识别并排除非己的功能,即免疫系统对“自己”和“非己”抗原性异物的识别与应答,借以维持机体生理平衡和稳定。
2、免疫防御(immune defense)免疫防御是机体排斥外来抗原性异物的一种免疫保护功能。
该功能正常时,机体可抵抗病原微生物感染,即抗感染免疫;异常情况下,反应过高会引发超敏反应,反应过低或缺如可发生免疫缺陷病。
3、免疫监视(immune surveillance)免疫监视是机体免疫系统及时识别、清除体内突变、畸变细胞和病毒感染细胞的一种生理功能。
若该功能失调,可导致肿瘤发生,或因病毒不能清除而出现病毒持续感染。
4、免疫自稳(immune homeostasis)免疫自稳是机体免疫系统维持内环境稳定的一种生理功能。
该功能正常时,机体可及时清除体内损伤、衰老、变性的细胞和免疫复合物等,而对自身成分则保持免疫耐受;若该功能失调,可发生生理功能紊乱或自身免疫性疾病。
5、固有免疫(innate immunity)固有免疫亦称非特异性免疫,是生物体在长期种系进化过程中形成的一系列防御机制。
固有免疫在个体出生时就具备,可对侵入的病原体迅速应答,产生非特异抗感染免疫作用;亦可参与对体内损伤、衰老或畸变细胞的清除,同时在特异性免疫应答过程中也起抗原递呈等重要作用。
6、适应性免疫(adaptive immunity)是指个体发育过程中接触特定抗原(决定簇)而产生,仅针对该特定抗原(决定簇)而发生反应。
由后天获得,具有特异性、记忆性、作用慢而强等特点。
4、淋巴细胞再循环(lymphocyte recirculation)淋巴细胞在血液、淋巴液、淋巴器官或组织间反复循环的过程,淋巴细胞在机体内的迁移和流动是发挥免疫功能的重要条件。
5、黏膜相关淋巴组织(mucosal-associated lymphoid tissue, MALT):主要包括扁桃体、阑尾和小肠派氏集合淋巴结以及呼吸道、肠道和泌尿生殖道粘膜上皮细胞下聚集的无包膜的淋巴组织。

免疫沉淀技术技术简介:蛋白质作为生命形态中最重要的分子,一直以来都是全球科学家们研究的焦点。
免疫沉淀技术是以抗体与抗原间的专一性为基础用于研究蛋白质相互作用的经典方法,也是确定两种蛋白质在细胞内相互性生理作用的有效方法。
表现为可溶性抗原与相应抗体在液相或凝胶中特异性结合后,形成的免疫复合物在一定条件下出现蛋白质析出。
免疫沉淀与凝集反应、中和反应、补体参与的抗原抗体反应并称经典免疫学技术。
随着对蛋白质研究的不断深入,人们将免疫沉淀方法与其他方法相结合,在其基础上衍生出很多更为复杂的技术,使蛋白质分析方法更为多样化,应用范围更为广泛。
该技术现已广泛应用于基因、蛋白质以及其相互作用等研究领域。
免疫沉淀技术的发展:免疫沉淀技术的基本策略就是利用抗体与相应抗原的高亲和力特性检出和结合溶液中靶分子。
免疫沉淀技术从诞生起就一直随着科技的发展而进步。
早期,研究人员利用凝胶电泳分辨免疫沉淀蛋白,将抗原溶液加入琼脂糖之类的可渗透基质的小孔内,并在邻近孔内加入抗血清,随着抗原抗体扩散,大分子进入凝胶内,两者相互作用,形成由多个抗体分子与抗原桥联组成的复合物,通过抗体和抗原的扩散形成浓度梯度,并在最适浓度处形成多分子网络复合物,最终大分子蛋白复合物从溶液中析出形成肉眼可见的沉淀线。
免疫沉淀的早期改进方向是促进多聚体反应,使免疫复合物从溶液中析出。
随后,研究人员发现利用第二抗体与免疫复合物中的抗体形成网络结构,可以不必对每种抗原的第一抗体进行滴定实验,这种方法一直沿用至今。
20世纪70年代中期,人们开始采用固相反应,利用固定在金黄色葡萄球菌表面的蛋白A吸附抗体,再与相应抗原结合。
随着科技的发展,目前这种方法已改进为利用表面固定了蛋白A或蛋白G的微球来分离抗原抗体复合物,以达到检测抗原或目标蛋白的目的。
免疫沉淀技术的分类:本专题资料由海狸纳米科技(苏州)有限公司提供并参与校对。
海狸发源于美国麻省理工学院生物医学工程中心。
公司以具有自主知识产权的前沿生物纳米表面技术为根本,定位于生命科学研究、生物医药研发和疾病诊断行业的全球市场,专注于多个领域的高端生物耗材和生物纳米材料的产业化。

免疫学发展史就简单介绍来看免疫学发展史可分为 1. 经典免疫学时期:对人体免疫功能的认识首先从抗感染免疫开始,从18世纪末至20世纪中叶,随着微生物学的发展,人们对免疫功能的认识从人体现象的观察进入了科学实验时期。
2. 近代免疫学时期:20世纪中叶—60年代,由于近代免疫生物学的进展和细胞系选择学说的提出,否定了长期以来机体免疫反应是对外源抗原的特有反应,是单纯的化学过程的学说,认为免疫反应是机体识别“自己”和“非己”的普遍生物学现象。
3. 现代免疫学时期:发现了胸腺的免疫功能,确认了淋巴细胞系是重要的免疫细胞,阐明了免疫球蛋白的分子结构与功能,从器官,细胞和分子水平揭示了机体另一重要生理系统,即免疫系统的存在。
4. 免疫学已发展成为一门独立的生物学科.具体而言,可概述为:(一)免疫学开创阶段早在我国南宋时期,公元11世纪时,我国创造性地发明了人痘苗,即用人工轻度感染的方法,达到预防天花的目的。
这实际上是免疫学的开端。
至17世纪时,不但在我国已普遍实行以人痘苗接种预防天花,而且也引起邻近国家的注意,人痘法已传入朝鲜、日本及俄国,并由俄国传入士耳其,后经中东再传入欧洲。
1721年英国驻土耳其公使夫人Montagu将人痘法传入英国,在英国曾进行了人体实验;把接种人痘者移居至天花流行区,结果发现接种者均获得免疫力。
(二)免疫学的兴建阶段继人痘苗以后,免疫学上的一个重要的发展是Jenner首创的牛痘苗。
他观察到挤牛奶女工得过牛痘以后,就不再得天花的事实,通过长期的研究,证实牛痘苗可以预防天花。
牛痘给人接种后,只引起局部反应,对人的毒力并不增加。
因牛痘苗对于人体无害,以后它就完全代替了人痘苗。
自Jenner发明牛痘苗后,免疫学的发展停滞了将近一个世纪。
到19世纪末,由于微生物学的发展,相继地发现了许多病原微生物,免疫学也随之迅速发展。
其中Pasteur受到人痘和牛痘苗的影响,通过系统研究,找到用理化和生物学方法,使微生物的毒力减低,以减毒株制备菌苗或疫苗,如炭疽菌苗、狂犬病疫苗等。
免疫学技术实验指导硕士研究生使用上海交通大学医学院免疫学教研室2010年11月免疫学实验须知本课程是以实验为主的综合技术性课程,旨在提高和发掘同学们的创造性思维及实验操作能力,培养同学们严谨、严肃、求实、创新的科学作风。
通过实验教学力求使同学们掌握免疫学技术的基本原理、基本方法与基本操作。
为此,对所有参加本课程的同学特要求如下:1.参加本课程学习的同学,在每次实验前务必认真预习本实验指导,对实验的原理、操作方法和实验用的器材、试剂以及预期的实验结果必须做到“心中有数”。
2.参加本课程学习的同学,在进入实验室时应自觉穿好白大衣,保持实验室环境的安静和整洁,遵守课堂秩序。
3.参加本课程学习的同学,在实验过程中必须爱护实验器材与设备,节约实验试剂。
使用贵重仪器时应该获得指导教师的许可和指导。
如遇器材损坏或其它意外情况应及时报告指导教师。
4.参加本课程学习的同学,在实验完成后必须按照指导老师的要求,清洗、整理好实验器具,并按要求妥善处理各类实验废弃物。
5.参加本课程学习的同学,在实验完成后应按照指导老师的要求,本着实事求是的科学精神,详尽完成实验报告,并能对实验结果做出一定的分析与讨论。
目录第一章抗原获取与抗体的制备 (3)实验一免疫球蛋白的分离与纯化 (4)实验二动物免疫与佐剂制备 (6)第二章体外抗原抗体反应及其应用 (8)实验三凝集抑制试验—妊娠试验 (9)实验四双向琼脂扩散试验—免疫球蛋白鉴定 (10)实验五免疫电泳—免疫球蛋白鉴定 (11)第三章免疫标记技术 (12)实验六荧光抗体标记 (13)实验七酶联免疫吸附试验(ELISA)—双抗体夹心法 . 14 实验八酶联免疫吸附试验(ELISA)—间接法 (15)第四章免疫细胞的检测 (17)实验九外周血单个核细胞的分离—密度梯度离心法 (18)实验十外周血T细胞的数量检测—E-花环形成试验 (20)实验十一淋巴细胞表面抗原检测—免疫荧光法 (22)实验十二细胞膜表面抗原检测—补体依赖的微量淋巴细胞毒试验24实验十三NK细胞杀伤功能检测 (26)第五章细胞因子检测 (28)实验十四肿瘤坏死因子检测 (29)附录:免疫学技术实验常用试剂配方 (31)第一章抗原获取与抗体的制备在以抗原和抗体的特异性结合为基础的免疫学应用技术中,抗原的获取与抗体的制备构成了免疫应用技术的重要基础。